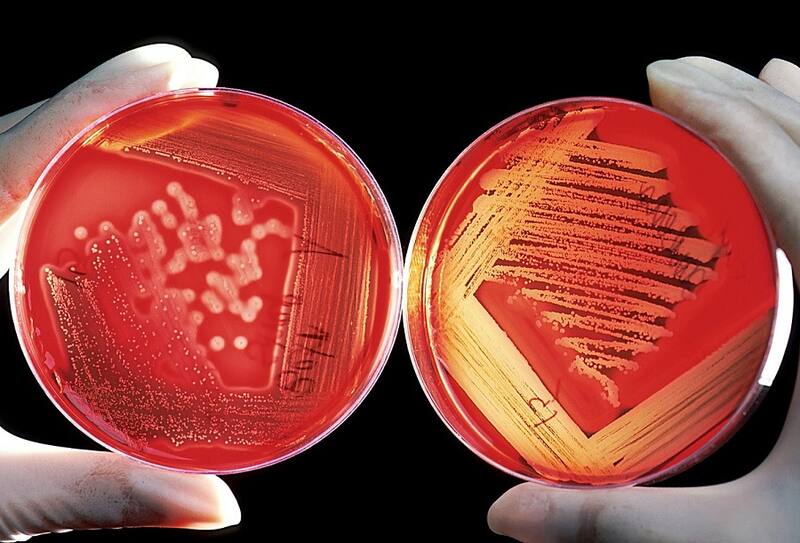

¿Aún no has tenido Covid? Podría ser algo más que suerte
Así como la genética podría ser un factor determinante de la gravedad de la enfermedad, nuestra composición genética también puede ser la clave para la resistencia a la infección por Sars-CoV-2.

Todos conocemos a algunas de esas personas afortunadas que, de alguna manera, han logrado evitar contraer Covid. Tal vez usted es uno de ellos. ¿Será algún una superpoder al estilo Marvel? ¿Hay alguna razón científica por la que una persona pueda ser resistente a infectarse, cuando el virus parece estar en todas partes? ¿O es simplemente suerte?
Más del 60% de las personas en el Reino Unido han dado positivo por Covid al menos una vez. Sin embargo, se cree que la cantidad de personas que realmente se infectaron con el Sars-CoV-2, el virus que causa el Covid -19, es mayor. La tasa calculada de infecciones asintomáticas varía según el estudio, aunque la mayoría está de acuerdo en que es bastante común.
Pero incluso teniendo en cuenta a las personas que han tenido Covid y no se han dado cuenta, es probable que todavía haya un grupo de personas que nunca lo hayan tenido. La razón por la que algunas personas parecen inmunes al Covid es una pregunta que ha persistido durante la pandemia. Como ocurre con tantas cosas en la ciencia, no hay (todavía) una respuesta sencilla.

Probablemente podamos descartar la teoría de un superpoder de Marvel. Pero es probable que la ciencia y la suerte desempeñen un papel. Vamos a ver.
La explicación más sencilla es que estas personas nunca han estado en contacto con el virus.
Sin duda, este podría ser el caso de las personas que se han estado protegiendo durante la pandemia. Las personas con un riesgo significativamente mayor de enfermedades graves, como aquellas con afecciones cardíacas o pulmonares crónicas, han tenido un par de años difíciles.
Muchos de ellos continúan tomando precauciones para evitar una posible exposición al virus. Incluso con medidas de seguridad adicionales, muchas de estas personas terminaron con Covid.
Debido al alto nivel de transmisión comunitaria, particularmente con las variantes de Ómicron extremadamente transmisibles, es muy poco probable que alguien que vaya al trabajo o a la escuela, socialice y compre no haya estado cerca de alguien infectado con el virus. Sin embargo, hay personas que han experimentado altos niveles de exposición, como trabajadores de hospitales o familiares de personas que han tenido Covid, que de alguna manera han logrado evitar dar positivo.
Sabemos por varios estudios que las vacunas no solo reducen el riesgo de enfermedad grave, sino que también pueden reducir a la mitad la posibilidad de transmisión doméstica del Sars-CoV-2. Entonces, ciertamente, la vacunación podría haber ayudado a algunos contactos cercanos a evitar infectarse. Sin embargo, es importante tener en cuenta que estos estudios se realizaron antes del Ómicron. Los datos que tenemos sobre el efecto de la vacunación en la transmisión de omicrones aún son limitados.
Algunas teorías
Una teoría sobre por qué ciertas personas han evitado la infección es que, aunque están expuestas al virus, no logra establecer una infección incluso después de ingresar a las vías respiratorias. Esto podría deberse a la falta de los receptores necesarios para que el Sars-CoV-2 acceda a las células.

Una vez que una persona se infecta, los investigadores han identificado que las diferencias en la respuesta inmunitaria al Sars-CoV-2 desempeñan un papel en la determinación de la gravedad de los síntomas. Es posible que una respuesta inmune rápida y robusta pueda evitar que el virus se replique en gran medida en primera instancia.
La eficacia de nuestra respuesta inmune a la infección se define en gran medida por nuestra edad y nuestra genética. Dicho esto, un estilo de vida saludable ciertamente ayuda. Por ejemplo, sabemos que la deficiencia de vitamina D puede aumentar el riesgo de ciertas infecciones. No dormir lo suficiente también puede tener un efecto perjudicial en la capacidad de nuestro cuerpo para combatir los patógenos invasores.
Los científicos que estudian las causas subyacentes de la Covid grave han identificado una causa genética en casi el 20% de los casos críticos. Así como la genética podría ser un factor determinante de la gravedad de la enfermedad, nuestra composición genética también puede ser la clave para la resistencia a la infección por Sars-CoV-2.

Investigo la infección por Sars-CoV-2 en células nasales de donantes humanos. Cultivamos estas células en platos de plástico a los que luego podemos agregar virus e investigar cómo responden las células. Durante nuestra investigación, encontramos un donante cuyas células no podían infectarse con el Sars-CoV-2.
Descubrimos algunas mutaciones genéticas realmente interesantes, incluidas varias relacionadas con la respuesta inmune del cuerpo a la infección, que podrían explicar por qué. Se ha demostrado previamente que una mutación que identificamos en un gen relacionado con la detección de la presencia de un virus confiere resistencia a la infección por VIH. Nuestra investigación se basa en un pequeño número de donantes y destaca que todavía estamos raspando la superficie de la investigación sobre la susceptibilidad genética o la resistencia a las infecciones.
También existe la posibilidad de que una infección previa con otros tipos de coronavirus resulte en una inmunidad de reacción cruzada. Aquí es donde nuestro sistema inmunitario puede reconocer el Sars-CoV-2 como similar a un virus invasor reciente y lanzar una respuesta inmunitaria. Hay siete coronavirus que infectan a los humanos: cuatro que causan el resfriado común y uno que causa Sars (síndrome respiratorio agudo severo), Mers (síndrome respiratorio de Oriente Medio) y Covid.
La duración de esta inmunidad es otra cuestión. Los coronavirus estacionales que circularon antes de 2020 pudieron volver a infectar a las mismas personas después de 12 meses.
Si ha logrado evitar el Covid hasta la fecha, tal vez tenga inmunidad natural a la infección por Sars-CoV-2, o tal vez haya tenido suerte. De cualquier manera, es sensato seguir tomando precauciones contra este virus del que todavía sabemos tan poco.
*Lindsay Broadbent, investigadora de la Facultad de Medicina, Odontología y Ciencias Biomédicas, Queen’s University Belfast
COMENTARIOS
Para comentar este artículo debes ser suscriptor.
Lo Último
Lo más leído
1.
⚡¡Extendimos el Cyber LT! Participa por un viaje a Buenos Aires ✈️ y disfruta tu plan a precio especial por 4 meses
Plan digital +LT Beneficios$1.200/mes SUSCRÍBETE